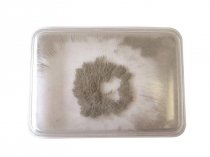
IRON FILINGS BUBBLE

Commotion
Supports the following areas of learning: • Physical Development - motor skills...
Large clear digital display, times up or down in 1 second increments. Maximum time 99...
Supports the following areas of learning:
• Physical Development - motor skills
•...